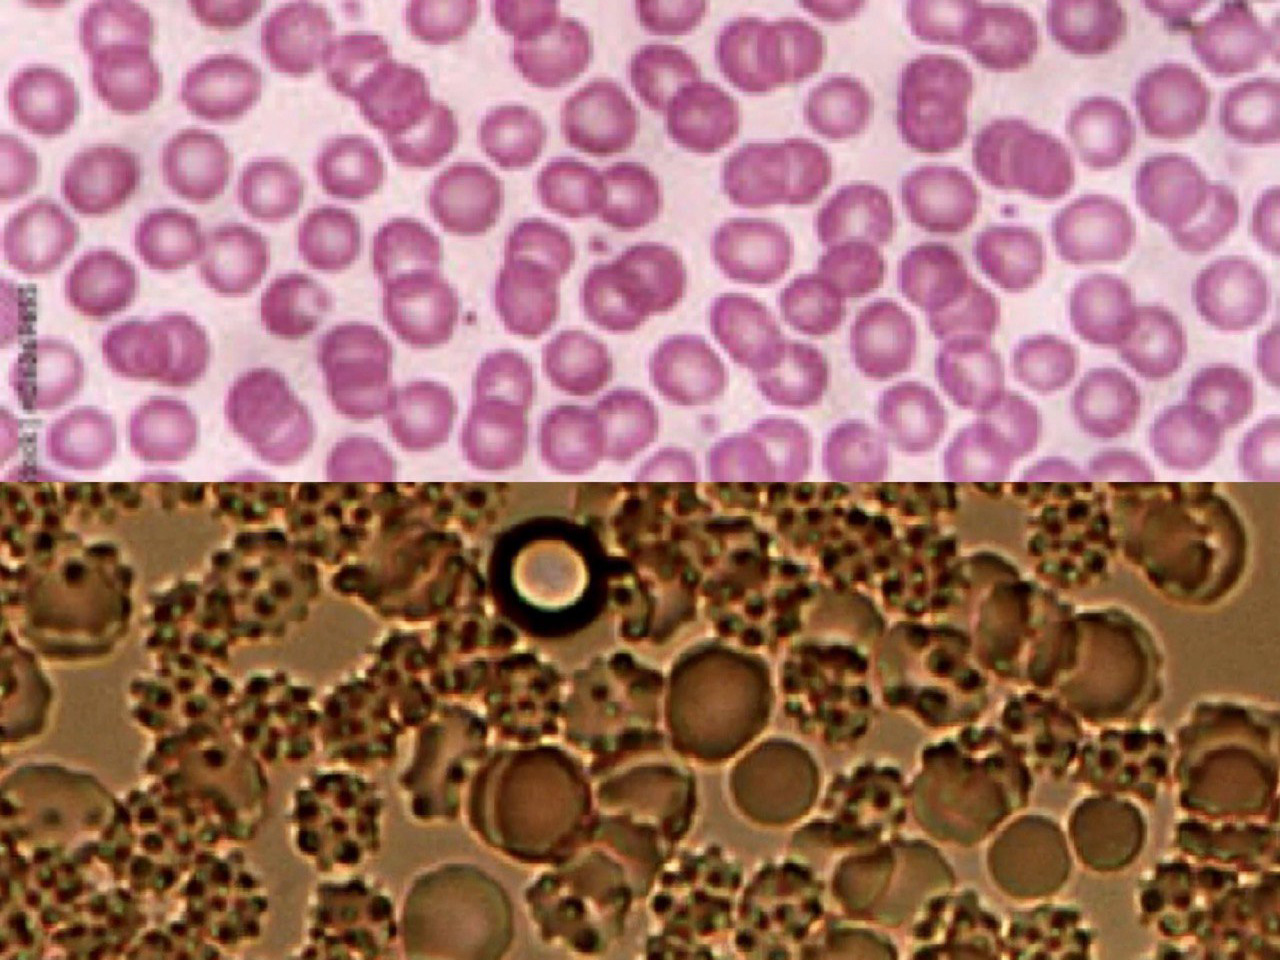

In einer Welt, in der die mRNA-Technologie rasant und ohne umfassende Langzeitstudien Einzug in viele Lebensbereiche gefunden hat, stellt sich eine grundlegende Frage: Wie sicher ist unser Spenderblut?
Immer mehr Berichte, Ärzte und kritische Stimmen warnen inzwischen davor, dass auch in Blutspenden mRNA enthalten sein könnte – insbesondere dann, wenn der Spender „geimpft“ wurde. In Zeiten, in denen fast die Hälfte der Weltbevölkerung mRNA-basierte Substanzen injiziert bekam, ist die Wahrscheinlichkeit, bei einer Operation auf sogenanntes „verseuchtes Blut“ zu treffen, alles andere als gering.
Was früher ein selbstverständlicher Vertrauensakt war – eine lebensrettende Bluttransfusion –, wird nun zu einer ethischen und gesundheitlichen Herausforderung. Denn: Niemand weiß mit Sicherheit, ob und wie sich mRNA-Rückstände im Blut halten, übertragen und möglicherweise auf den Empfänger übergehen können – insbesondere, wenn es sich um genmodifizierende Substanzen handelt, die die Proteinbiosynthese beeinflussen.
Das Rote Kreuz – einst quasi Hüter des Lebens – geriet selbst in den Fokus kritischer Fragen.
Vereinzelt gab es Hinweise, dass einige Landesverbände kein geimpftes Blut wollten oder entsprechend kennzeichnen wollten – doch die Transparenz blieb aus. Spenderblut wird…
Zusatz-Quelle: https://t.me/MeineDNEWS/33532
Geimpftes Blut Bilder: 1, 2, 3 (verklumpt, Röhrchenbildung)
Bild: freepik.com

Band 6 – Kontrolle, Biotechnologie & die verborgene Macht
„In Band 6 tauchst du ein in die verborgenen Strukturen unserer Zeit: Biotechnologie, Impfstoffe, transhumanistische Entwicklungen und gesellschaftliche Kontrolle. Erfahre, wie moderne Technologien unser Leben, unsere Gesundheit und sogar unseren Körper beeinflussen – und wie du mit Bewusstsein und Wissen deinen eigenen Weg findest. Mit kritischen Perspektiven, tiefgehenden Analysen und praxisnahen Einsichten.
Willst du dieses und viele weitere Kapitel vollständig lesen und Klarheit gewinnen über die Kräfte, die unsere Welt prägen.“

